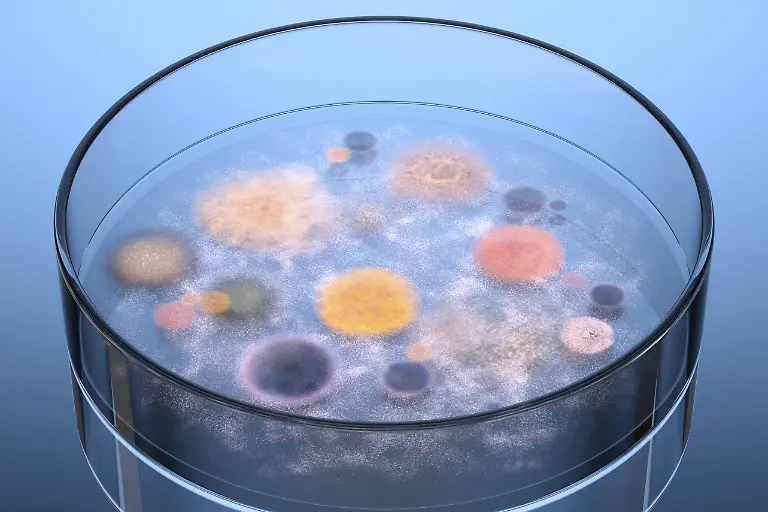
imago62797576h

Bilderserien

Besonderheiten der EvolutionVerrückte Überlebensstrategien
18.04.2015, 10:15 Uhr
Hauptsache überleben! Dieser Grundsatz ist das höchste Gebot in der Natur. Manche Tierarten haben darum erstaunliche Fähigkeiten entwickelt. Die außergewöhnlichsten sind in einer Ausstellung im Naturkundemuseum in New York oder hier zu bestaunen.